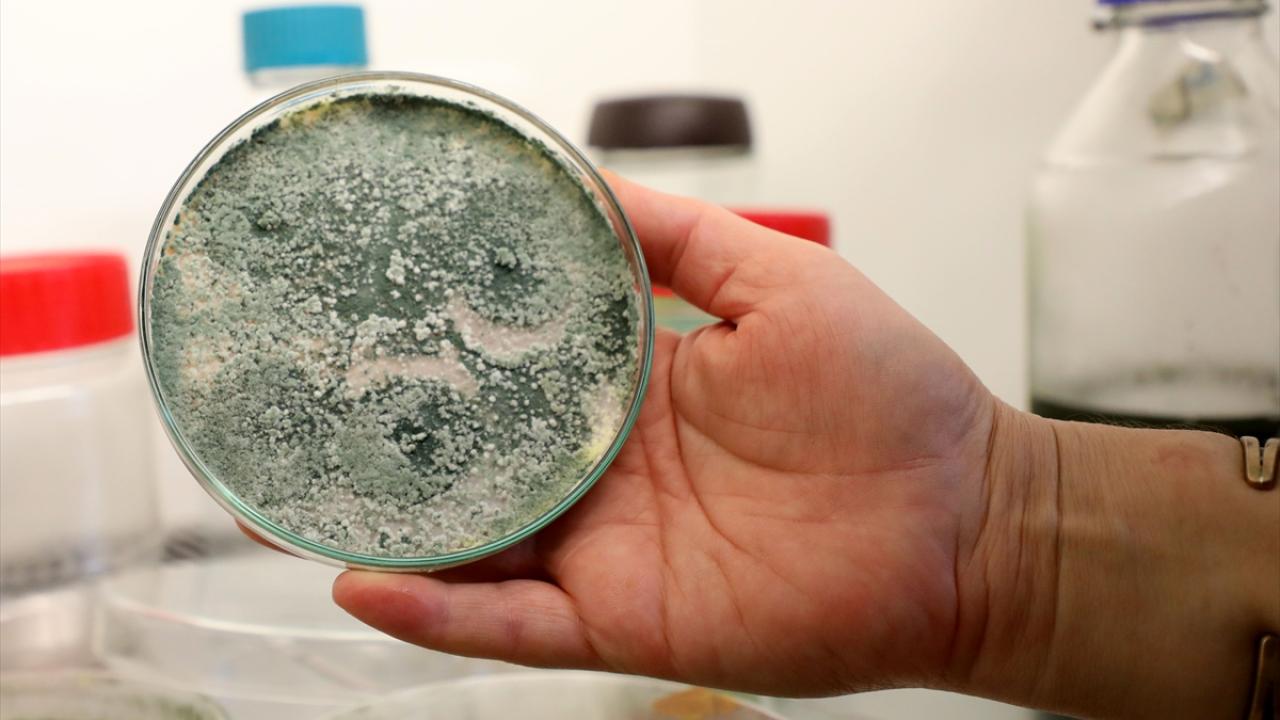

Dünya Doğayı Koruma Vakfının (WWF) koruma altına alınması gereken 200 ekolojik bölge arasında gösterdiği alandaki ağaçlarda 2010 yılından sonra mantar ve şimşir yanığı hastalığı tespit edildi.

Hastalık sonrası şimşirlerin gövde ve dallarında çürümeler, odun dokusunun niteliğinde bozulma ve zaman içinde ağaçlarda kuruma baş gösterdi.

Akademisyen ve uzmanlardan oluşan 7 kişilik çalışma grubu, TÜBiTAK tarafından desteklenen "Şimşir Ağaçları Hastalık Etkenine Karşı Biyolojik Mücadele" projesini hayata geçirdi.
2019 yılında "hayalet orman" olarak adlandırılan şimşir parkında henüz can suyunu kaybetmemiş şimşir ağaçlarının yeniden yeşermeleri ve canlanmaları için biyolojik mücadele yürütüldü.

Recep Tayyip Erdoğan Üniversitesi (RTEÜ) Fen Edebiyat Fakültesi Biyoloji Bölümü Mikrobiyoloji ve Moleküler Biyoloji Anabilim Dalı Başkanı Prof. Dr. Şengül Alpay Karaoğlu öncülüğündeki akademisyenlerin 3 yıllık kurtarma çalışmasından sevindirici haber geldi.

Bölgenin toprak florasından elde edilerek çoğaltılan biyolojik kontrol ajanı mantarlar hazırlandı. Hazırlanan kür yılda üç kez ağaçlara ve toprağa uygulanarak yararlı mantar türünün popülasyonu artırıldı ve hastalık etkenlerinden korunması sağlanmaya çalışıldı.

Yapılan 3 yıllık çalışmanın ilk evrelerinde can suyu bulunan şimşirlerin yeşerdiği, sağlıklı yapraklar oluşturduğu ve yeniden tohumlandığı gözlemlendi.

Uygulamanın, şimşir ormanlarındaki hastalık etkeni mikroorganizma miktarının zararsız seviyelere düşene kadar devam ettirilmesi hedeflenirken, Karaoğlu, doğada artan mantar popülasyonunun ağaçlara telafisi zor zararlar verdiğini söyledi.

Türkiye`ye 2010 yılında İngiltere`den girdiği tahmin edilen istilacı orman zararlısı "şimşir yanıklığı" etkeni mantarların tüm dünyada şimşir ormanlarının yok olmasına yol açtığını aktaran Karaoğlu, ağaçların mantarların yanı sıra "şimşir güvesi" ile de mücadele ettiğini kaydetti.

"Mücadele ağaçların ölmesini engelledi"
Karaoğlu, Kaçkar Dağları Milli Parkı içerisindeki orman kitlesinin başka bir yerde olmadığına işaret ederek, sözlerini şöyle sürdürdü: "Dünyada eşi benzeri yok. Hayalet orman haline dönmüş. Birinci etken mantar hastalığı ama halk arasında tırtıl diye adlandırılan böcek de istila etmiş. Milli Parklar Genel Müdürlüğü ekipleri tırtıl ile ışık tuzaklarıyla mücadele başlatmıştı. 2019`da başlattığımız biyolojik mücadele sonucu o seneki canlı kalan ağaç sayımız ile şu anda canlı kalan ağaç sayımız arasında çok az bir fark var. O yıllarda 130-140 ağaç canlıydı. Bugün 120`ye yakın ağaç canlı. 3 yılda yaptığımız mücadele ağaçların ölmesini engelledi, canlı tuttu."

Bölgede çok sayıda ölü ağaç olduğunu ve en büyük tehdidi oluşturduğunu kaydeden Karaoğlu, şöyle devam etti: "Ölü ağaçların her biri hastalık etkeni mantar için bir yuva. Biz ne kadar mücadele etsek de bu ağaçlar içerisindeki hastalık rezervi mantarlar bizim mücadelemizi baltalıyor. Ağaçlar diyor ki `Biz inat ediyoruz. Siz de bize destek verirseniz biz kurtulacağız.` Çünkü tepede canlılık halen sürüyor. Mücadele edilen ağaçlardaki yosun miktarı azalmış, ağacın gövdesindeki kabuk soyulmaları bitti. İlk kez bu yıl çok mutluyuz. Yoğun bir kış yaşadık ve bize çok desteği oldu. Bu sene ilk kez tohum verdi. 100 ağacın verdiği tohumu, her bir ağaçta 100 tohum olsa her biri yeni tohum, yeni filiz demek. Bu tohumların yeniden yeşerebilmesi için hastalık etkeni olanı uzaklaştırmak gerekiyor."

Karaoğlu, ölü ağaçların getirmiş olduğu mantar yükünün yaşayan ağaçları kısa sürede istila edebileceğine dikkati çekerek, "Bu açıdan ormanın tamamen rehabilite edilebilmesi için ölü atıkların toplanması, temizlenmesi gerekiyor. Biz yılda üç kez biyolojik mücadele ediyoruz. Ara dönemlerde de kireç atılarak bütün istilacı türlerle mücadele edersek ve 5 yıl sürerse burası yeniden yeşerebilir, eski haline dönebilir." ifadelerini kullandı.

Dünyada ormanlık alanlara giren ziyaretçilerin dezenfekte edilmiş havuzda el ve ayaklarını yıkadıktan sonra alana girdiğini belirten Karaoğlu, aynı uygulamanın bu bölge için de gerekli olduğunu söyledi.

"Ağaçlarda bolca tohumlanma var"
Prof. Dr. Karaoğlu, şimşir ormanlarını 2004`ten itibaren gözlemlediğini ve alanda çalıştığını ifade ederek, şunları söyledi: "2010 yılından itibaren ağaçlar mücadele ediyor, yaşam savaşı veriyordu. Dolayısıyla tohum için gerekli enerjisi yoktu ama uyguladığımız biyolojik materyal ona tohum üretebilecek enerji sağlamış ki ilk kez bu sene tohum vermiş. 2010-2014 yıllarında alanda fotoğraflarımız var. 2019 yılından itibaren alanı gözlüyoruz ve bir tane tohum bulamamıştık. Bu sene yeni küçük filizlerde hem de ağaçların tepe bölgesinde bolca tohumlanma var. Bu bize çok büyük bir nimet, şans. Yeniden yeşermenin bir umudu. Yaptığımız uygulamanın doğru olduğunu gösteriyor. Ağaç immun direncini oluşturmuş, `Benim sağlığım iyi. Size tohum da veriyorum. Yaşamaya devam edeceğim ama lütfen siz de bize destek olun.` diyor."

Karaoğlu, projeye Doğa Koruma ve Milli Parklar ekiplerinin önemli destek sağladığını kaydederek, alanın yeniden yaşaması için sonuna kadar mücadele edeceklerini sözlerine ekledi.





